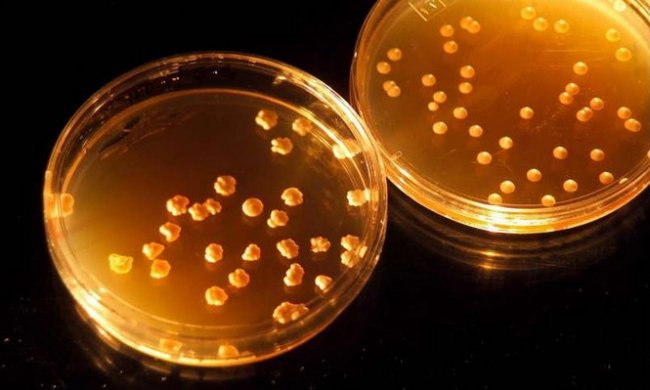

NASA: учёные позаботятся о пище для марсианских колонистов - «Космос»
✔ Испокон веков космос привлекал людей. Именно поэтому человек дал название сотням звезд, разделив их на десятки созвездий. Именно поэтому Галилей придумал телескоп, именно поэтому Гагарин сказал «Поехали!». По той же причине поверхности Луны и Марса бороздят различные исследовательские аппараты, на границе Солнечной системы космические зонды изучают отдаленные планеты, а на орбите Земли находятся МКС и телескопы Кеплер и Хаббл. Все потому что космос привлекает людей, как и все непонятное и неизведанное. |
Могут ли земляне выжить на Марсе? Могут, если обеспечат себя продуктами питания. НАСА поставило перед командой специалистов из разных университетов, включая Университет штата Юта, создать технологию производства пищевых продуктов, пригодную к реализации на Марсе.
Биохимик Лэнс Сифельдт и ботаник Брюс Багби станут во главе создаваемого Исследовательского института космических технологий, на который НАСА выделяет 15 миллионов долларов. Сифельдт, работающий профессором на факультете химии и биохимии в Университете Юта, оценил проект как невероятно новаторский. «НАСА стремится выйти за пределы околоземной орбиты и инвестирует исследования, которые сделают возможными длительные экспедиции», - сказал он.
Говоря о проблемах, с которыми столкнутся колонисты на Марсе, Сифельдт подчеркнул, что путешествие к Красной планете может занять до двух лет. Снабжение по линии Земля – Марс будет медленным и очень дорогим, поэтому астронавтам придётся самостоятельно производить пищу, медикаменты и создавать объекты инфраструктуры для этих производств.
Багби, который работает в должности профессора факультета растений, почв и климата Университета Юта, также отметил дороговизну доставки грузов на Марс. Он сотрудничал с НАСА в течение 30 лет, разрабатывая системы регенерации и микрогравитации для выращивания растений.
Даже в богатой азотом атмосфере Земли выращивание растений, пригодных в пищу, является нетривиальной задачей. Лишь около века назад немецкие химики Хабер и Бош изобрели способ связывать азот для получения необходимых растениям удобрений. Как же будут колонисты на Марсе решать гораздо более трудную задачу?
На Марсе им придётся работать с углекислым газом и небольшими объёмами водорода и воды, отметил Сифельдт. К счастью, современные технологии, основанные на ископаемом топливе, позволяют пойти дальше разработок Хабера и Боша. Переработка азота в аммиак будет осуществляться бактериями. Для этого процесса необходим лишь солнечный свет, которого на Марсе достаточно.
Если барьер получения удобрений будет преодолён, в дело вступят технологии профессора Багби. Он помогал астронавтам выращивать растения на космических челноках и Международной космической станции (МКС). Эта работа могла быть остановлена 12 лет назад, когда НАСА прекратило финансировать исследования. Но Багби и его коллеги, включая учёных из России, продолжали отправлять в космос семена и ростки на российских космических аппаратах.
«Главной проблемой будет выращивание продуктов в малой замкнутой системе. Если мы создадим полностью замкнутый цикл использования воды, удобрений, газов и остатков растений, то в перспективе мы можем постепенно перейти на использование марсианских почв», - сказал Багби.
Учёный добавил, что даже при успешном создании сельскохозяйственного производства на Марсе, рацион колонистов будет строго вегетарианским. Выращивание животных продуктов будет слишком дорогим. Некоторые учёные вообще предлагали рационы на основе витаминов, воды и обезвоженных продуктов, однако Багби считает, что воздействие такого питания на организм изучено недостаточно.
Сифельдт особо отметил, что будущие технологии будут предназначаться не только для Марса. «Здесь, на Земле, в таких местах, как засушливые районы Африки, мы не можем применить технологии вековой давности для получения достаточного количества протеинов, чтобы накормить людей. Возможно, разрабатываемые методы позволят решить эту проблему», - сказал профессор.
Источник: phys.org
И будьте в курсе первыми!